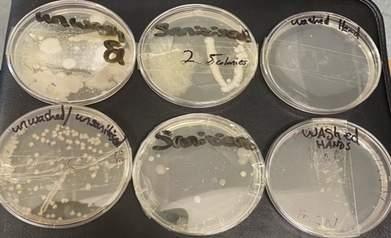

ScienceJournal2023



























Iamdelightedtowelcomethefirst editionoftheWWETBScienceJournal. Thisinitiativecamefromour DirectorateofSchoolssectionled byEimearRyanandhugeworkhas beendonetoseethisthrough bySinéadO’HaraandAnne-MarieToomey Thanks also to leaders and teachers from schools and centres who contributed their time to this project including teachers of STEM subjects who are past pupilsofourschools.
The momentum for this work was assisted by the inclusionintheWWETBStrategicStatement2018-2022 of various actions designed to develop interest, student take-up and quality learning in the STEM subjects of Science, Technology, Engineering and Mathematics ThenewStrategyStatement2023-2027 willimplementgoodplanstobuildonthiswork
The outcomes from our STEM Research Grants to schools have been a great assistance in promoting this project; students and teachers have shown great dedicationandenthusiasmforthesciencesubjectsin thisregard.
Congratulations to all involved in this innovative project
Iwouldliketowelcomethethe firstWWETBScienceJournaland congratulatebothlearners,staff andcollaboratingpartnersfor theworkdoneonitsproduction TheWWETBstrategicplanhas identifiedthesupportingof learners in the exploration of science and the scientific method as something we believe is important It is great to see this reflected in the work identified throughout the journal. I believe the WWETB Science Journal will serve as a reference document going forwardforbothlearnersandstaff
Editors: SineadO'Hara,EducationCoordinator(Schools)
Anne-MarieToomey,DigitalLearningSupport
Designby:
Anne-MarieToomey,DigitalLearningSupport




WelcometothefirstWWETB ScienceJournal,which records notonlytheresearchprojects undertakeninourschools,but alsohowschoolleadersand teachersofSTEMsubjects encourage students to actively participate their learning
One of the most exciting aspects of STEM subjects lies in the realm of research. Through research, students acquire invaluable skills such as observation, experimentation, and data analysis, preparing them for a multitude of exciting opportunities Undertaking research in a group develops many other skills such as collaborating with others and communicating effectively WWETB is delighted to have provided Science Research grants for students to undertake research projects andweareveryproudofwhattheyhaveachieved. WWETB schools promote STEM subjects for many reasons as STEM education opens a vast array of career possibilities, extending far beyond the stereotypical image of a scientist in a lab coat Whether students have a passion for space exploration, medicine, environmental conservation, technology, engineering, or even art and design, a strong foundation in science equips them with the tools to pursue their dreams From astronauts to doctors, engineers to marine biologists, and beyond, science serves as a gateway to an incredible range of professions that can make a positive impact on the world Moreover, STEM subjects empower students to understand the world around us, unravel its intricate mechanisms, and make informed decisions that shape our future Itisalsoclearfromthecontentinthisjournal that our students have fun while learning We hope that in some way our support for this project and journalwillcontributetothatempowerment "Scienceisawayofthinkingmuchmorethanitisa bodyofknowledge."-CarlSagan
Wearedelightedtohavetheopportunityto shareexamplesoftheinnovativeworkof teachersfromacrossWWETB collegesand centres and highlight the very encouraging engagement of our students in all things STEM! STEM education changes society by offering learners a new mindset and skills valued in any profession ThankyoutoeveryonefeaturedinthisJournalforall yourhardwork.
November11th,2021sawthelaunchoftheMarineBiodiversityCitizenScienceandLeaving Cert Biology Ecology(Hedgerows as Habitats) programmes which were developed for learnersinWWETBschoolsandcentresbytheNationalBiodiversityData Centre SpeakingatthelaunchinDungarvanYouthreach,CEofWWETB,Mr KevinLewis thankedDrLiamLysaght,DirectoroftheNationalBiodiversityDataCentre,forhis support in building this partnership with WWETB Cllr Barbara Anne Murphy, Chairperson oftheBoardofWWETB,reiteratedthecommitmentoftheBoardtosupportingtheworkof schoolsandcentresonbiodiversity,sustainabilityandonenvironmentalissues DesignedbyMrDaveWall(CitizenScienceOfficer)andMrOisínDuffy(Surveysand RecordsOfficer)inconsultationwithteachingstaffandmanagementfromWWETB, these modules will further enhance the teaching of Science across the Leaving Certificate, the Leaving Certificate Applied, Transition Year and Junior Cycle curricula Maria Carney, Youthreach Coordinator, outlined how learners in the centre are already piloting the Citizen Science module, with great success Cllr Leonard Kelly said that this collaborative piece of work was important for the learners and gives us all chance to become Citizen Scientists As Michael O’Brien, Innovation and Development Manager in WWETBoutlined,recordingsgatheredbylearnerswillfeedintothenationaldatabaseand assuchwillhelpusbetterunderstandandassisttheprotectionofIreland’sbiodiversity






Dave Wall introduced ‘Explore your Shore – Citizen Scientist’ at Clonea Beach in Dungarvan to WWETB teachers This included coast visits and an introduction to the classroom resources, video lessons, workbook, field visits and learner missions and challenges The marine exploration course formed the LCA Practical Achievement Task as it involved field studies and new skill development. The course was positively received and very relevant to the lives and interests of the learners It identified Biodiversity and Citizen Scientist, life on the seashore, rocky shore molluscs and invertebrates,bivalves,fishandbiodiversitysurveys Thereis further capacity to run the course during the Youthreach summer programme as there is ample opportunity for coastline and ocean exploration and developing a new awarenessofmarinebiodiversityissuesandmissions

In2020,WWETBwasdelightedtoannouncetheintroductionofaresearchfundingprogrammeforstudentsof STEMsubjectsinourpost-primarycolleges.
The aim of the programme is to offer students the opportunity to experience the research process from applicationstagetofinalreportsubmissioninthedisciplinesofScience,Technology,EngineeringandMaths For the purposes of this grant, a research project is defined as an independent investigation by a group of students involving experimentation or research to answer a scientific question The research can be directly relatedtothecurriculumoronaseparatetopic
Since the programme began three years ago, we have awarded 12 STEM Research Grants to classes across ourpost-primarycollegesandourCommunityNationalSchool
Wehaveincludedsomeofthefinalreportsinthisnewsletter Moretocomeinournextedition!Welldonetoall involved
Title: To investigate the pH, temperature, phosphate, carbon dioxide and oxygen levels of the River Slaney in Enniscorthy andcomparingtheseresultswiththeairquality

Team:3Alderandteacher,Ms.Ann-MarieEnglish
Hypothesis:forthestudyisthattheriverSlaneydoesnothave high levels of phosphates and so the levels of dissolved oxygenwillnotbelowerthannormal
Conclusion: Originally this project was due to take place in January 2022 January usually has lower temperatures and therefore more fossil fuels are used to heat homes releasing carbon dioxide into the air Due to Brexit and Covid-19 pandemic,theequipmentorderedwasdelayedinitsdelivery
Our hypothesis was that there would be correlation between air quality and water quality There was a weak correlation between PM 25 and pH and PM 10 and pH Our second hypothesis that the river Slaney did not have high levels of phosphates and so the levels of dissolved oxygen would not belowerthannormalseemstobecorrectfromourdata
If we were to repeat this experiment we would measure atmospheric carbon dioxide in the air We would also try different kits to measure phosphate ions and carbon dioxide ions to verify our results. We originally planned to do this experiment in January, It would be interesting to see how our resultsfromAprilwouldcompare

Wereallyenjoyedcarryingoutthisinvestigation Wewouldlike to thank the WWETB Science Research Fund for giving us the funds to carrying out this study We would like to thank PreScience PLC student Natalie for carrying out the dissolved oxygenprocedureeachmorningforus
Notefrom theSTEMResearchGrantAwardingCommittee:Studentsandtheirteacherprovidedacomprehensive10page researchreportontheirfindings Thefullreportcanberequestedbyemailingscienceresearchgrant@wwetbie

Research Title: Testing the effectiveness of hand sanitisation versushandwashing
Team:TransitionYearStudentsandteacher,MrPatrickMcDonnell
Conclusions:
•Theaveragecolonycountfromsamplingsanitisedhandswas 33colonies
•Theaveragecolonycountfromsamplingunwashed/unsanitised handswasTNTC
•Theaveragecolonycountfromsamplingwashedhandswas19 colonies
•Our results indicate that handwashing with warm water and soap is the best preventative method for reducing microorganismsonyourhands
•Sanitisingdoesreducethenumberofcoloniesgreatlybutthe resultsfromthisresearchsuggestthathandwashingisstillmore effectivethansanitising
Notefrom theSTEMResearchGrantAwardingCommittee:Studentsandtheirteachersubmitted anextensivePowerPoint presentationoutliningtheirresearchprocessandrationale Thefullpresentationcanberequestedbyemailing scienceresearchgrant@wwetbie

Aninvestigationeffectthatdifferentcolouredplasticcoverings willhaveonseedlinggrowth
TY Horticulture Team: Eimer Cowman, Darragh O’Donovan, KeiganByrne,JoshThatcher,RyanHayes,CarsonFitzpatrick, EmmaRaleighandteacher,MsMaireFinn


Hypothesis:Seedlinggrowthwillbeaffectedbythelightcolour thatshinesonit
Procedure:
1 Label6identicalpotswiththecoloursofplasticthatwill coverthem,labelonepotuncovered
2Place200gofsoilintoeachpot
3.Place10cressseedsintoeachpot.
4Watereachpotwith100cm3ofwater
5Covereachpotwiththeplasticcellophaneoftheparticular colourindicatedonthelabel
6Placeinthepolytunnel
7Watereveryseconddaywith50cm3ofwater
8Observeandrecordthegrowthofanyseedlings
9.Findtheaveragegrowthoftheseedlingsandrecordintable.
Conclusion:SeedlinggrowthisaffectedbythelightcolourthatshinesonitPurpleisthecolourthatproduces thegreatestgrowth,greenisthecolourthatcreatestheleastgrowth
Extension:ThisexperimentrequiresrepeattrialstoverifytheresultsWewouldalsorecommendusingdifferent seedsunderthesameconditionstocheckfordifferencesamongdifferentspeciesofplant

Title:Airqualityinclassrooms
Team:TYScienceclassandteacher,MsMargaretBrennan
Introduction:TheideawasbasedonthenewschoolCovid-19 rules, that all classrooms need to have some ventilation to preventthespreadofCovid-19 Thenumberofwindowsleft openvariedwitheachteacherWewantedtotestifhavingthe roomventilatedchangesthenumberofmicro-organismssuch asbacteriaintheair Thesciencelabwasdonatedanair sampler,sowedecidedtoputittogooduse,
Methods:
Wedidourexperimentsinafirst-yearclassroom Before classbegan,weleftallthewindowsopenfor4minswith nobodyinside
The class ran as normal for 30 mins, with 18 first year studentsandoneteacherWethenrantheairsamplerSAS
SUPER100withanAgardishinit
Weremovedtheagarpetridish,sealeditwithparafilmand placeditintheincubatorat30°for5days
Werepeatedthisprocess3times
Werepeatedthewholeprocesswith2windowsopenedand thenthreewindowsopened.
After the petri dishes were incubated, we counted the bacteriacoloniesoneachdish

Results:Thepetridisheswhichwereexposedtomorefreshair hadlessbacteriacolonies Lesscoloniesmeanbettertheair qualityandlesschanceofcontractingcontagiousdiseases
Extension: If we had more time we could explore the relationship between the number ofpeopleinandroomandtheairquality
WWETB Service to Business unit were delighted to support the National Apprenticeship Office (NAO) to promote apprenticeships at the annual Apprenticeship Expo 2023 held in the Knightsbrook Hotel, Trim, Co Meath23rdMarch2023

There were over 90 exhibitors and close to 4,000 attendees registered proving how prevalent apprenticeship is for post-primary school students, parents, employers, also demonstrating the accessible pathways to Further and Higher Education that apprenticeshiproutesareoffering
There are currently 66 apprenticeship options in Ireland withafurther23apprenticeshipsatdevelopmentstages with SOLAS The Apprenticeship Expo is organised and managed by County Meath Chamber in collaboration with, LMETB, Meath County Council, Regional Skills Training Centre Dundalk, SOLAS, INTREO and Regional SkillsMidEast,NorthEast&Dublin

Team:1stYearEngineeringclassandteacherMrGeoffreyCollins
TheschoolappliedforfundingfromtheWWETBScienceResearchGranttobuycomponentsforbuilding simplemodelmotorsthatwouldhelpstudentsunderstandhowanelectriccurrent,magnetandacoppercoil canproducearotationalforce IalsoinvestedinsomeBBCMicrobits TheBBCmicro:bitisapocket-sized computerthatintroducesyoutohowsoftwareandhardwareworktogether IthasanLEDlightdisplay, buttons,sensorsandmanyinput/outputfeaturesthat,whenprogrammed,letitinteractwithyouandyour world

WefeltthatitwasafantasticideaforthenewtopicofMechatronicsontheJuniorCycleEngineeringsyllabus asitrelatestocontrollingmotorsandmechanicaloutputs.
AmodulewasdevelopedthatinvolvedthestudentsdownloadingtheMicro:bitapporaccessingitvia websiteIscreenrecordedandnarratedthestepsinvolvedinprogrammingaMicro:bitandsentthemtothe studentsviamyYouTubechannel.Theywouldthenreplicateandfurtherdevelopthemovesanduploadtheir workonTeamsThisworktookplaceremotelyduringCovid-19schoolclosures
Studentslearnedhowtocreatescrollingtextdisplaysbypushingcertainbuttons,thenprogressedto programmingmotorstoturnclockwise/anticlockwise,timedelays
Nextwascontrolofservomotorstoturnthroughdefinedangles.
Uponreturningtoschool,thestudentsappliedtheirlearningtoprogramrealMicro:bitstodoallofthethings theyhadlearnedusingthePhoneAppsimulatorincludingactualroboticvehicles
Irecordedphotos,screenshotsandvideosalongwithstudentinterviewsthatwerecompiledintoanonlineinservicepackageusedbyJCTforupskillingEngineeringteachersnationallyWearedelightedthattheworkof ourstudentsisbeingusedbyJCT

ColáisteanÁtha

Title:Totestwhetherdifferentcolourshadanimpact onmemory.
Team: Senior Room and teacher Ms Jamie Lee Sommers
Method
Wedecidedtocarryoutthreeexperimentstoensure validity Thecolourswetestedwereblack,blue,red, yellowandgreen.
Experiment 1: We displayed a series of various coloured letters to the class on the board for 5 secondsWethenremovedthemfromtheboardand wehadtowritethelettersweremembered Wedid thisafewtimes
Experiment2:Variouscolouredcirclesweredisplayed ontheboardfor10seconds.Thenwehadtocolouras many correct colours in the correct places as we could
Experiment3:Thistime,theteachercalledoutrandom words that we had to write down in the different colours Thewordsheetsweretakenawayandwe hadtore-writewhatwordswecouldremember
Experiment 4: Different coloured images were displayedontheboardfor10secondsThenwehadto writedownwhatitemsweremembered
Experiment1:Variouslettersshownontheboard,in different colours We wrote down what we remembered
Experiment2:Wedisplayedcolouredcirclesonthe boardfortenseconds,thencolouredinblanksheets toseewhatweremembered
Experiment3:Differentwordswerecalledoutandwe wrotethemdownindifferentcolours.Thenthesheet wastakenawayandwehadtowritedownthewords weremembered
Experiment4:Picturesweredisplayedontheboard andwewrotedownwhatweremembered
DataCollection
Experiment1:Wehadtocounthowmanylettersfrom eachcolourpeoplegotcorrect Weputthisintoa tableandtallytomakeiteasiertocount
Experiment2:Wehadtocounthowmanycoloured circlesmatchedtheoriginal.Againwedecidedtouse atableandtallytomakeiteasiertocount
Experiment 3: We counted how many of each colouredwordwegotrighttofindadominantcolour
Experiment 4: We counted how many correct imageswerememberedandcheckedwhichcolour wasrememberedmost
Wecomparedthedatafromall4experiments
Result
Experiment 1: Black was the most remembered colour,followedcloselybyyellow Greenwasthe colourrememberedleast
Experiment 2: Black was the most remembered colour, followed by yellow Blue was the least remembered.
Experiment 3: Yellow was the most remembered colour, followed by black Red was the least rememberedcolour
Experiment4:Yellowwasrememberedmost,while redandbluewererememberedleast
Blackwasthemostrememberedcolourintwo experiments and yellow was the most rememberedintwoexperiments
Thepartofthebrainthatisresponsible formemoryistheHippocampus



Altogether, yellow was the most remembered colouroutofalltheexperiments. Whatdoesthismean?Wecoulduseyellowpens and text when we are learning to help us to rememberbetter! Memoryisveryimportantandthereareafew wayswecanlookafteritSuchas:
Beingphysicallyactiveeveryday
Stayingmentallyactive
Spendingtimewithothers
Stayingorganised
Eatingwell

WWETB, in partnership with SOLAS, (Further Education and Training Authority) is offering a scholarship programme in craft apprenticeships. The aim of the scholarship is to promote female participation in all 25 craftrelatedapprenticeships.

WWETB offers companies the opportunity to act as a host employer to a scholarship recipient, thus enabling them to receive the relevant workplace experience and industry knowledge to become a qualified craftsperson In conjunction with WWETB, participating companies will be involved in the recruitment and selectionprocessoftheapprentice Companieswhoparticipateinthescholarshipwillhavetheopportunityto improvetheircorporatesocialimage
If you are an employer reading this journal and would like to find out more information on becoming a host employer,pleasedonothesitatetocontactaseniortrainingadvisoronapprenticeshipscholarship@wwetbie
MathsWeekgotofftoagreatstartinSt Declan’swithaMaster LegoBuilderCompetitionforLegoEnthusiasts!Thiswasagreat opportunity for students to demonstrate creative building and problem-solving skills It encompassed skills undertaken in Science,Engineering,MathsandArt(theSTEAMsubjects)

Students’ work was of a high standard and the interpretation of their individual briefs was outstanding. A big thanks to Mr. Collins for judging the builds and congratulations to those who builtthe‘unsinkable’boat!!
As part of Maths week the TY students coordinated a Maths Bingo competition for all 1st and 2nd years Well done to all involved
The school had many in-class activities during Maths Week, whentheworldofMathematicsiscelebrated!
ThankstoMs DugganandalltheMathsDepartmentforrunning theevents.
AdrianPowerName: Currentlyworkingin: PrincipalBridgetownCollege
Whatdoyoulovemost aboutteachingyour subject(s)?
They were my favourite subjectsinschool
LunarCycles

ColáisteanÁtha

Wheredidyoustudytobecomea teacherofyoursubject?
UniversityofLimerick
BridgetownCollege
PastPupilof: No.ofyearsworking withWWETB:
16years
Subjectsyouteach:

CurrentlyPrincipal,previouslyI taughtWoodworkandConstruction Studies
Whatdoyoulikemost aboutteachingina WWETBschool?
Inclusiveeducationwith greatvaluesand understandingof studentsfromallwalks oflife
Inspirationtobecomeateacher?
TheteachersinBridgetownCollege inspiredandencouragedmeto pursueacareerinteaching
In January 2022, Third year Science students mademodelsofthelunarcycleusingOreos.


BridgetownCollege
Transition Year students took part in the inaugural SciFest competition in December 2020 Projects spanned a diverse range of research topics including testing the hypothesis that cows lie down in the rain Cllr Jim Moore, Michael O'Brien (WWETB) and Sinead O'Hara (WWETB) had the unenviable task of picking a winner on the day Cillian Duggan and Nathan Fitzpatrick were deemed the worthy winners, after lengthy deliberations by the judges Theirprojectstestedtheeffectivenessofvariousmethods of food storage for preservation The judges commented on the high standard and the enthusiasm the students had for their projects A great understanding of the scientificprocesswasdemonstrated
BunclodyVocationalCollege
For the second year in a row Bunclody Vocational CollegequalifiedtocompeteattheBTYoungScientist &TechnologyExhibition,theonlyschooltoqualifyfrom Wexford this year. The competition was held virtually from the 6th - 8th of January 2021 Huge congratulations are extended to the Science Department and to participating student Leah Coleman

ColáisteAbbáin
40% of Coláiste AbbáinJunior Cycle students are now studying a Short Course in Agriculture Thank you to everyone in the local community for embracing, developing and enabling this course to go from strength to strength We do believe the students' smilessayitall!!



Leah was also part of the team that won a Merit Award atlastyear’sevent ThisyearshecompetedintheSocial and Behavioural Science category and her contemporary project was entitled "Real-Time Analysis of The Effect of Lockdown on Post Primary Students in A DEIS School" While Leah did not receive any awards on this occasion, her research will contribute to the huge volume of data that has come out of students experiencesoflockdownduring2020.

Congratulations to Selskar College 6th year students, Elizebeth Shanto and Anna Zweirchowska who finished 2nd place in the Senior Category of the Annual Young Reports of the Environment National Competition with their article‘ContactlessCoffee’
YoungReportersfortheEnvironmentengagesstudentsinenvironment-focusedcitizenjournalism, lookingatissuesandsolutionsandreportingonthemthrougharticles,photos,orvideos ContactlessCoffeeaddressestheissuesarounddisposableandtake-awaycoffeecupsandoffers solutionstothisgrowingproblem CongratulationstoElizebethandAnnaonthisamazingachievement!


ThreeTransitionYearstudentsfromBunclodyVocational College recently completed a Science Laboratory placement in Maynooth University This hands-on laboratory-basedweekfocusedonareassuchasevolution, immunology, and environmental science. Participating students were provided the opportunity to carry out techniques in Microbiology, Biochemistry & Molecular Genetics The programme gave the students a great opportunity to see scientists in action researching in laboratories.
This was a fantastic experience for students as accommodationwasalsoprovidedTheygotarealtasteof collegelifewhilelearningmanylaboratorytechniquesand skills. Bunclody Vocational College is delighted to have securedthreeplacesonthisprestigiousprogrammefor next year so are already appealing to budding young scientists especially those who may be interested in a careerinthisarea SpecialthankstoMs BrennanandMs Finn for accompanying the students and making this fantasticopportunitypossible
The following account was provided by Kellie Cloke participatingstudent
“The experience that I had at Maynooth University was amazingandoneofakind!Itwassointeresting,engaging, andinspiring IwouldliketosayabigthankyoutoMs Brennanforthisamazingopportunity,andtoMr Murphy andtheWWETBforfundingthistrip Ilovedlearningabout evolution,immunology,microbiology,andgenetics.Itwas veryinterestingtolearnallthetechniquesthatareusedin biochemistry, microbiology, and genetics It was an amazingexperiencebeingabletobearoundsomegreat peoplewhoareverypassionateaboutwhattheydo”
29th September 2022 - “Tubes Up Day” for GLOBE Ireland These tubes will detect nitrogen dioxide pollution at 3 locations around the school The schoolplanonsharingresultswhenareavailable



Ms. Walsh and Ms. Bowdren’s Science students took part in the Globe Air Quality program which is monitoring Nitrogen dioxidelevelsacrossIrelandandglobally



Youth Train CTC in Wexford town jumped at the chance once again, to collaborate with Wexford County Council asapartnerforScienceWeek2020
Learners worked as a team with scientist Michelle Maher to experiment and innovate with ideas on sustainable energy projects. While young people may feel strongly about issues such as the climate crisis, they feel that they need more than a lobbying voice Michelle’s approach to learning about energy was the theory that its easier for learners to understand when they design anddeveloppoweredvehicles,rocketsandturbines This project involved designing and building solutions for real world issues, in this case sustainable energy generation and storage It was empowering and practical with learnersaskingthequestionsthemselvesandlookingfor solutionstogether.Theprojectprovokedquestionsabout thesciencebehindthingstakenforgranted,imagininga more sustainable future, which is more sympathetic to theenvironment
Learning in this way can enhance employability with knowledge gained in skills working as a team on critical thinkingandinnovationtasks
Congratulations to Transition Year students

Fionn Bowdren and Ultan McCusker who won second prize in the sustainability category at the STEPS Engineering workshops
WWETB Services To Business Unit are pleased to announce the South County Wexford craft apprenticeship trowel trades scholarship in the followingapprenticeshipsofPlasteringorBrickand StonelayingorStoneCuttingandStoneMasonrywith thepermissionofthescholarshipbenefactor

The scholarship is to the maximum permitted expenditureof€20,000overamaximumperiodof4 years
If you would like to find out more information or receive an application for this scholarship, please contact a WWETB senior training advisor on servicestobusiness@wwetbie
Youth Train works with young, creative learners aged 16-21 who achieve confidence and qualifications in CTC’s to progress to further education and employment Youth Train learners work to achieve QQI qualificationsatLevels3and4fundedthroughWWETB and with backing from the Irish Government and the European Social Fund, there is recognition of the value of enabling access to STEM learning, especially those whomayhavemissedoutonthisexperiencebefore
Leaving Certificate Biologystudentshaving some fun learning the namesandlocationsof bones!

Somewoodworkstudentshavebeenbusyinrecentweeksdesigningandmakingtheselittlesteppingstools Ideal for a younger siblings to reach the kitchen counter top easier, to help with baking, to sit and watch tv, anextrabedroomseat,etc.WelldonetoallbuddingdesignersandcraftspeopleinDungarvanCollege.



CareerSummitatSETU St.Paul'sCommunityCollege
5thyearstudentsattendedthecareersummitatSETUon 27th April, 2023 They got lots of information about apprenticeships, going to college and joining the army, navy and the guards They also got to meet lots of representativesfromlocalbusinesses

The National Reptile Zoo visited the school before midterm for a very informative workshop with TY students They learned more aboutanimalinteraction&care, habitats, anatomy morphology and adaptation They also had the opportunity to get up close to a Boa constrictor, scorpion, cornsnake&atortoise

WWETBEnniscorthyFabLabhasbeenupandrunningsince July2018,providingcreativetrainingintheCADsoftware incorporating,AutodeskCAD,InventorandRevit
Theprogrammehasdesignedmanydifferentprototypes forindividualstofulfilproductdesignThisentailscreating 3Dsimulationsand3Dprintedpartsofdesigns


In2021EnniscorthyFabLabteamedupwiththeWexfordMen’s ShedinRedmondSquare,Wexford,to3Dprint10different figurinestoplaceintoChristmascribswhichthegroup createdAllproceedsfromthesaleofthesecribswere donatedtotheHopeCentreinEnniscorthy

EnniscorthyFabLabisexpandingitsoperationsbyestablishing another training room in the Enniscorthy Enterprise and TechnologyCentre Thisroomwillcontain3Computerised Numeric Control (CNC) machines; a Milling, Lathe and a Routermachinealongwith6trainingspaces
Theaimofthisfacilityistotrainindividualsandcompany employeesintheskillsofoperatingCNCMachines. ThisnewfacilitywillenabletheWWETBEnniscorthyFabLabto teamupwithInstituteofTechnologyCarlowtodeliveroneof itsLevel6coursesinManufacturingandDesignEngineering withtheWWETBFabLabdeliveringtheCNCsectionofthe course
After a wonderful tour of the FABLAB in Enniscorthy with John O’Leary earlier this summer, the Services to Business (STB) Unit embarked on an exciting collaboration with both the Enniscorthy and New Ross FABLABS A huge part of the STB unit’s work is to monitor all apprenticeships throughout Waterford and Wexford The unit had been looking for a unique marketing tool for the apprenticeship programme and the FABLAB had the perfect solution - its 3D printers. A project was developed to create a 3D letter A that would represent each industrywithintheapprenticeshipprogramme,16'A'sintotalcoveringall66apprenticeshipscurrentlyavailable The attention to detail on each piece is amazing with the colour allotted to each industry and its emblem etched on each A The finished collection is fantastic and has been the focal point of every exhibition it has beenattodate AhugethankstoJohn,KamalandtheteamsatbothFABLABS

Digital Learning ran an O365 Digital Cluster competition open to all Transition Year students acrossour12WWETBschools.Studentscreateda2to 3 minute video on ‘My Digital Footprint’ for the target audienceofpostprimarystudents

Congratulations to all 7 schools that participated in thecompetition:BridgetownCollege,ColáisteanÁtha, Creagh College, Dungarvan College, Enniscorthy Community College, St Declan’s Community College andSt Paul’sCommunityCollege


Congratulations to the winners Coláiste an Átha and the team of: Lucy Creavin, Faye Fitzpatrick, Seanna Purcell, Joanne Hyland, Cheyenne Dolan, Caitlin Dempsey, Molly Lanney, Emmy Kennealy and Brian TomkinsandcooperatingteachersJamieMurphyand
ShaneMurphy
Congratulations to the runners up: Creagh College andSt Declan’sCommunityCollege

Thejudgescommentedontheveryhighstandardofthe productionandthecontentofallthevideos All participantsreceivedacertificateofparticipationfor enteringthecompetition
Fortheirprize,50TransitionYearstudentsfromColáiste anÁthatravelledtoOneMicrosoftPlace,DublinonFriday 24thMarch2023,andparticipatedinaseriesofDream Spaceworkshops-teambuildingactivities,explored variouscomputerprogrammingtasksusingMicro:bits andadiscussiononpotentialcareeropportunitiesThey alsohadlunchandatouroftheMicrosoftbuilding. ThankyoutotheMicrosoftDreamSpaceteamfor hostingtheworkshopandtheITDepartmentofWWETB forsponsoringtheprize.
LCA learners in Dungarvan Youthreach were keen to explore environmental issues as part of their Leaving Certificate Applied course Two key biodiversity actions based on marine and plant life were selected The competing demands of centre life, often means that initiativesneedtosynchronisewithcurriculumneedsto beanimatedandprioritised WWETBhadjustformedl inkswiththeNationalBiodiversityDataCentre Thecentre became involved with a new innovative programme ‘Explore Your Shore – Citizen Science’ In addition, ECO UNESCO had publicised a competition for schools based on Youth Environmental Actions Both initiatives were used to scaffold the centre in achieving its biodiversity goals

ECO UNESCO organise the Youth Environmental Awards which is a national competition for schools to promote environmental awareness In 2022, Dungarvan Youthreach won the award for their Biodiversity Healing Garden (Eco-Community Development -Senior category).TheaimoftheECOUNESCOawardistoempoweryoung peopletomakepositiveenvironmentalchange

The whole centre community created a native wildflower garden using local seeds and natural resources for community use The garden is adjacent to a local graveyard and many people find a moment to reflect and enjoy the space Among many actionoriented tasks, the learners researched, designed and created a native wildflower garden Art teacher Maria Conroy steered her classtodesignagardeninagreenfieldsitebyaddingnativetrees, plantsandshrubs.Theyaddedbirdboxes,re-cycledmaterials,and employedlocalseedharvestingmethods.Theirprimaryaimwasto highlighthowgardenscanbeahealinghabitatonmanylevelsand biodiversity is of primary importance The class further amplified theirmessageaboutbeesandpollinationtohundredsofchildrenin localnationalschoolsbyorganisingaBeesArtcompetitionandthe centreisnowa‘Nosprayschool’
The project was a great opportunity for community engagement
The project formed the LCA General Education Task and the ECO UNESCO award was the highlight of the year and a major national achievement for Dungarvan Youthreach learners and staff. After months of creative environmental action, Art teacher Maria Conroy andherclasspresentedtheproject‘TheHealingGarden’toapanel of judges on the ECO Den and they proudly claimed their beautiful prize

NewPygmyGoats
ColáisteAbbáin
There was great excitement in Coláiste Abbáin on 31st Januray, 2023 as they welcomed the first baby Pygmy goats of theyear Alittlegirlandabrazingboy

BridgetownCollege
In October 2022 - Modelling inheritance - new species produced by 3rd Years by determining the genotypesandcorrespondingphenotypesfromtheparentchromosomestheyhad.Fabulousnewoffspring produced!





ColáisteanÁtha
February2023,TransitionYearstudentsinactionontheirNumeracyProjects.



SelskarCollege
In March 2023, 5th year students visited SETU to walk in the shoes of an SETU Architecture student fortheday
ColáisteanÁtha

Ms Reddy’s 1st year Art students worked on the Wexford County Council Wildflower poster competition Students learned about wildflowers in Wexford and the process of ‘Cyanotype’ Students picked wildflowers from the school grounds and made Cyanotype (solar prints) of them as part of their posters Cyanotype utilisestheUVraysinthesuninordertoprintthewildflowersontopaper Itistheoldestformofphotographic printing




To coincide with the school taking part in the Climate and Nature Summit 2022, the Transition Years took the message of climate changetothestreetsofBridgetown!
The Green Building/ASD Class organised a ClothingDonationDayinMay,2023.

In November 2022, the school took part in the Climate and Nature Summit 2022 The ClimateandNatureSummitisaseriesofFREE engagingonlinesessions



Itisanopportunitytocreate a space for a whole school climate and nature conversation during the UN Climate Change Conference, COP27 This year ’ s summit encouraged teachers and students to consider the psychology of climate, climate policy in Ireland and the tremendous opportunities to build a thriving economy, vibrant communities and a more resilientworld
In October all first years took part in a fun workshop called 'Bin It!' It was a lively afternoon of raising awareness about binningourrubbish



March2023-Studentswerebusy prepping beds, planting bulbs andenhancingthebiodiversityof the community! The seedlings were looking vibrant as they prepare to head out to their community as part of the 'Edible Towns project' with Wexford EnvironmentalNetwork

As part of #take1week226thyearStudentsengagedwith SDG 15 (life on land) and SDG 11 (sustainable communities) Students surveyed the school grounds and chose locations to increase Biodiversity by planting springbulbs


The Selskar College school community is always looking for opportunities to get involved with the wider community in positive ways Fifth Year Art students began work on a creative arts project in Whites Hotel, where they hope to raise awareness and promotebiodiversity

ForEnergyAwarenessDay2022, students,staff,theSelskarCollege GreenSchoolscommitteeand variousclassgroupsparticipated intalkson:EnergyUseinthe Home,LightingDisplay,Insulation (Walls,Attic), Handouts/Temperature cards/GuideandGrant information
Students from 3 Connacht homemade card and some Irish grown plants as a thank you to Monica for presenting the Climate Literacy course This programme was funded by WexfordLocalDevelopment

In January 2023, third year class Connacht hosted a Water Awareness week As part of week they hosted a Poster competition Leo, Vanessa and Sophie created these three fantastic posters to raisedawarenessacrosstheschoolcollege




May2023,WaterAwarenessWeekwasaweekpackedwithfun,factsandinformation
Theweekbeganwithastudentsurveyonhouseholdwaterusage,followedbyaquizon ourknowledgeofwateranditsusesandorigins
Thursday saw a vessel of water on display with the competition to guess the correct amount of litre and millilitrescontainedinit



TheFridayfinalebroughttheculminationofeventswithanice-creamsurpriseforeachstudentwhoshareda factonwater
Studentsalsoheardatipeachdaytohelpconservewaterinschoolandathome

Studentsalsoconductedwaterflowtestsandinspectedwaterdevicesforleaks
A special thanks to Assistant Principal II with responsibility for Sustainability and Student Voice, Mr Barry, for coordinatingevents
Well done to all of the prize winners from Water Awareness Week in May 2023. Congratulations to all our studentsfortheirengagementandparticipation


1st year classes have had a busy Spring, preparing a "metre of meadow" to enhance biodiversity in the school, partnering with Wexford Environmental Network "edible town project" to grow vegetables in local community and engaging with #ESD through Sustainability workshops The school's “metre of meadow” is even more valuable because oftheirurbansetting

January Sales with a difference at Bunclody Vocational College Well done to the Student Council who organised a swap shop where students and staff donated items and picked out something else to freshen up their new yearwardrobe!Theeventwasahugesuccess with students really getting on board the sustainabilitytrain


Special thanks to food group company ABP Slaney who have donated a number of native Irish trees to Bunclody Vocational College The aim of this initiative is tohelpthelocalareatoexpandits biodiversity areas The Transition Year Horticulture class, under the watchful eye of Ms. Brennan, greeted this campaign with open arms and are pictured here planting some of the trees supplied



The Community Garden is transforming into a beautiful space Thanks to all who have helped out so far The groupmeetseveryTuesday,

In November 2022, the school took part in the Climate and Nature Summit 2022 The Climate and Nature Summit is a series of FREE engaging online sessions It is an opportunity to create a space for a whole school climate and nature conversation during the UN Climate Change Conference, COP27 This year ’ s summit encouraged teachers and students to consider the psychology of climate, climate policy in Ireland and the tremendousopportunitiestobuildathrivingeconomy,vibrantcommunitiesandamoreresilientworld.
Congratulations to our two 1st year students, Nicole Walsh and Jack Finnegan,whowontheGreenSchoolsTravelcompetition


Onthe7thMarch2023,the4thYearSVPgrouporganisedtheVincent’sPopUpShop Theyencouragedstudents tobringin‘preloved’clothing/itemsfordonationfortheirshop





In April 2023, LCA1 students created some fabulous planters in Agriculture/Horticulture class A lot of time andeffortwentintothesecreativedesigns





5th May 2023 - the school welcomed the newly hatched ducklingstotheflock


Firstyearscompletedasustainabletextilesproject
85925bottlessavedfromlandfill!

Therefillstationhasbeenagame-changer for the school Before its installation, students and staff alike were buyingsingle-useplasticwaterbottlesonadailybasis,resultingin a significant amount of waste But now, anyone can refill their reusablewaterbottlesthroughouttheday,cuttingdownonplastic wasteandpromotingamoreeco-friendlylifestyle

Not only is the water refill station environmentally friendly, but it's also a cost-effective option Refilling your bottle is significantly cheaper than buying a single-use plastic water bottle every time you need a drink. By encouraging students and staff to bring their reusable water bottles to school, the school is not only reducing plastic waste but also promoting a culture of sustainability and responsibility Thankyoutoallofourstudents!
CreaghCollegesYoungSocialInnovators setupaSwapShop Theshopswapwas openonThursday9thandFriday 10thMarch.


Theaimwastoopenaswapshopat Creaghtoreducetheenvironmental impactoffastfashionpurchases
Students were looking for donations of pre loved clothes in goodconditionforexamplecoats,jumpers,trousers,shoes, tops,dresses,skirts,accessories,etc
Junk Kouture entry Chasing Rainbows by LeahMcGowan,LilyWatters&RoisínByrne
The name of the design is Chasing Rainbows because the students felt that it suited our piece as our dress is colourful The main theme for materials were toys because they realised the amount of children's toys that just get thrown away and aren’t being used anymore 90% of toys sold today are made from plastic and this has a big impact on pollution. To actually put the idea together they cut up toys, sewed old clothes into flowers, used old wool to make pom-poms and repurposed an old corset, shoes and an umbrella They sewed, tied, stapled and hot gluedtheirdresstogether

January 2023 - Well done to TY students Caoimhe Creavin, Ruby Rellis, Molly Brady, Lucy Williams and Katie Nolan who participated inthefirstphaseofThePeople'sTransitionModelcarriedoutbyMr Kieran Harrahill, from TASC and facilitated by Aileen Walsh HSCL ThePeople'sTransitiondescribesamodelforparticipativedecision makingthatisintendedtoenableacommunitytobenefitfromthe transitiontoazero-carbonsociety



Onthe16thNovember2022-ECCwelcomedMEPGraceO’Sullivan who hosted seminars and question and answer sessions with Leaving Certificate and JCSP students on the topics of Climate Change and the EU response and the meaning and role of the EuropeanUnioninthe21stcenturyworld
The visit was part of ECC’s obligations as a partner school of the European Parliament Ambassadors Schools Programme to highlightthemissionandworkoftheEuropeanUniontostudents
October 2022 - A new Polytunnel Club came to the rescue of repairing the polytunnel and began clearing the ground and doing preparatory work prior to the installation of theplasticcovering
On the 10th October 2022 - As part of their Sustainability module, theTransitionYearstudentsvisitedRegan’sOrganicfarminCaim



The students met the owner, Mary Mary gave them a tour of the farm and told the students about the process of changing the farm over to Organic, which took two years, as this is the length of timeittakesforpesticidesetctoclearfromtheground
Studentssawthecowsgrazingintheirbeautiful,lushsurroundings, as well as the Llamas and donkeys, whose manure is put to good use on the compost heaps. In the polytunnels they learned about thedifferentstagesofbringingvegetablesfromseedtomaturity.


As part of Science Week some students took part in a webinar run by Teagasc, focusing on women in STEM.
DrCasKramer presentedan interactive explorationof DNAaspartof ScienceWeek Thankyouto Calmastforthis opportunity,The firstyear studentsreally enjoyed themselves


WWETBEngineeringTeachersincollaborationswithSETU-Micro:bitMasterClasses
Digital Learning facilitated the collaboration between Engineering Teachers from WWETB and South East Technological University (SETU).
The teachers involved participated in Micro:bit Master Classes with SETU Electronics lecturer, Jason Berry Jason hosted the Master ClassesaspartoftheUniversity’soutreachprogram
The teachers got a tour of the Engineering Technology Applied Robotics Lab. Jason showed the group past and current student projects Final year students presented their projects The students and lectures shared their experiences and ideas with the teachers Jasonandtheteacherssharedideasontheteachingandlearningof Micro:bit technology It is an exciting collaboration between the University and the WWETB Engineering teachers which we hope to developandstrengtheninthecomingacademicyear

Wheredidyoustudytobecomea teacherofyoursubject?
Name:

Currentlyworkingin: St Paul'sCommunityCollege
Whatdoyoulovemost aboutteachingyour subject(s)?
The fact that answers are rightorwrong,notsubjective
PastPupilof:
St Paul'sCommunity College
No.ofyearsworking withWWETB:
Almost19years!!!!! Wherehasthattime gone??
Whatdoyoulikemost aboutteachingina WWETBschool?
Being part of a larger team

BridgetownCollege
Incredible1styearearthandspaceprojects!Great efforteveryone



UCC-BAMaths&ComputerScience
Subjectsyouteach:
CurrentlyDeputyPrincipal Maths
Inspirationtobecomeateacher?
Some of my past teachers, in particular my own Maths teacher, PaulDuggan



Science week was celebrated in styleatBunclodyVocationalCollege. The students spoke to Professor English in her Immunology lab at NUI Maynooth via zoom The Science department ran several competitions during the week including: model making, quizzes andposterdesign Theweekfinished withavisitfromthefantastic Dave's Jungle. Students and staff were introduced to some interesting and exotic creatures Huge thanks to Ms Brennan, Ms Finn and Mr O’ Leary for all their work in ensuring a very enjoyableweek
The school had a VR Workshop during Science Week, where some students and teachers got a taste of virtual reality. Huge thanks to Ms. Keane for introducing this fun element to our students



For Science Week, Transition Years were given the opportunity to gain experience working with young people and teachSciencetosomeofthe1styears Theyplannedandtaughttheirveryownlessonstotheirpeers Itissafeto say Coláiste Abbáin have some excellent future teachers in the making Well done to Lauren, Veronica, Ella, Rebecca,SarahandKaitlyn




The Science Department and the Transition Years organised a science quiz week for secondyearstudents

The Science department were very busy in Creagh College for Science week Bunscoil Loreto and Educate Together National School visited to learn about acids and bases. Great fun was had by allinthelab AbigthankyoutoalltheTY students who helped out The teachers were also busy collecting projects from first years who hope to win one of Creagh College's Science scholarships


Below is an example of one of the projects from first year student Ryan Harpur Well done everyone who submittedaproject.

TYstudentsenjoyedtheopportunitytotakepartintheCSIexperience Theyspentthemorninglearningaboutfingerprinting&howitisused in solving crime, how to analyse trace evidence and how DNA holds the key to almost everything. A crime scene was set up in the afternoon which allowed students to experience a Crime Scene Investigation Thehighlightwasdonningthefullgearbodysuit
1st year students had a two hour Lego Robotics workshop as part of Science Week 2022 Students worked in teamstobuildarobot.Theythenprogrammedtherobottoperformvariouscommands.



SeniorstudentshadagreatdayoutatDublinZootodaywiththeirbiologyteachers,MsCDoyleandMsRyan



During National Science Week, Enniscorthy Community College ran a number of competitions to promote Science Including:colouring,acrostic,Dingbatsandriddlescompetitions





ColáisteAbbáin
InJanuary2023,the Transition Years hand crafted their own custom pens as an extra curricular activity. Students developed their skills using the lathe and the laser engraving machine to etch in their namesonthepens



Students were rewarded for cracking codes, winning quizzes, designing rockets and most importantly, helping out throughouttheweek
6th year Biology students wowed Junior Cert Science studentswithfantasticdemonstrationsofexperiments!










Members of 2A and 2S took part in the TIMMs (Trends in International Mathematics and Science) study TIMMS assesses the maths and scienceskillsof4thclassand2ndyearstudents internationally every three years Well done to everyonewhotookpart




NZEB hosted Construction Studies students during Science Week TheNZEBteamshowcasedsustainabilityinbuildings, and highlighted the various apprenticeships that are available


AhugecongratulationstoallofthefirstyearstudentswhoparticipatedinSciFest competitionduringScienceWeek

KevinBarry Name:
Currentlyworkingin:
SelskarCollege
Wheredidyoustudytobecomea teacherofyoursubject?

UniversityofLimerick-BachelorofScience withconcurrentTeacherEducation
Subjectsyouteach:
Physics,Biology&Science
Inspirationtobecomeateacher:
PastPupilof:
BridgetownCollege
No.ofyearsworking withWWETB:
There was definitely a combination of factors which inspire to become a teacher Firstly, my insatiable desire to understand the world around me, this was framed by positive experiences of Science education in Ms Cole's science class which gave me confidence and belieftopursueSciences Finallyagentlepush in the right direction from my Mam who gave me focus and purpose on my journey to becomingateacher 12years
Whatyoulovemostaboutteaching yoursubject(s)?
I'm a passionately inquisitive person by nature and I believe Science education lends itself creative, engaging studentled learning experiences where students can explore and develop an understanding of the nature of reality and that's pretty cool in my opinion! I think the opportunities to foster a love of learning are abundant intheSciencelabsofourschools
Whatyoulikemostabout teachinginaWWETBschool:

Ibelievethatworkingwithin theWWETBhasfacilitateda strongsenseofcommunity andsupport,affordingmany opportunitiesforstafftogrow anddevelopthrough communitiesofpracticeand professionallearningnetworks
ColáisteAbbáin
In December 2022 - first year woodworkers enjoyed getting in the festive spirit designing and creating their own unique decorationsfortheirtrees




On the 22nd November 2022, the Green Schools Committee went on a trip to the Mayglass Water Treatment Plantandtookpartina beach clean in Kilmore Quay Thanks to Wexford County Council for facilitating the trip andSSErenewablescommunityfundforgivingagranttobuylitterpickers

In November 2022, the junior members of the Green Schools committee took part in a water workshop run by Green SchoolsIreland Lotsoffunbutalsovery informativeandthoughtprovoking




FantasticnewsforBridgetownCollege Theyhavebeenawardeda secondgreenflag ForthelasttwoyearstheGreenSchools committeehasbeenworkingonthethemeofwater Welldone everyone

Onthe15thNovember2022,Ms Cardiff,Ms LawlessandTosia Swierczynska,aGreenSchool’sCommitteerepresentative, collectedtheGreenFlagforSchoolsAwardattheWexford CountyCouncil EnvironmentAwards 2022intheFerrycarrig Hotel,Wexford TheyalsoreceivedanestboxfromWexford Naturalists’FieldClubaspartoftheiraward Congratulationsto the GreenSchool’sCommittee,teachersandalloftheschool communityontheirhardworktoachieveColáisteAbbáinnow havetheirfirsteverGreenFlag

On the 24th January 2023, Jack Redmond, Miacha Connolly, Eva Luchian(3Holly)andCodyWilliams(1Holly)wereaccompaniedby Ms Áine Sheeran and Ms Sarah Walsh to the 12th Annual "Neat Streets" conference in the Aviva Stadium today Neat Streets is an anti-litterprogrammeforsecondaryschools EnniscorthyCommunity College are one of only 31 schools nationwide participating in the programme


To start the day, triple Olympic sailor Annalise Murphy recounted her experiences with litter pollution in our oceans She identified findings fromanexperimentsheconductedwhilecompletinga9monthrace aroundtheworldonthe"TurnTheTideonPlastic";microplasticswere identified in waters from every part of the globe, including waters off Antarctica.
Next, the students had an interactive session where they met with students from other schools They discussed waste and litter issues, had a walking debate, and played a kahoot quiz Enniscorthy Community College won the Kahoot quiz and won 'Neat Streets' logo hoodiesfortheirschool!

Thenextguestspeaker,KevinMurphy,entrepreneur,founderandCEO of '2GoCup' talked about Circular Economy, which was the theme of the conference this year His innovative use and return cup is cost effectiveandsustainable.
Finally the students had to develop a business idea from a repurposeditemtheyuseeveryday Theypitchedideastoreuseand repurpose old tyres, schoolbags, headphones, books to name a few The Enniscorthy Community College students repurposed old bikes forhomeownersorbusinessownerstorenovatetheirlivingandwork spaces They proposed that the frames of old bikes could be melted down and used to make furniture, embracing the idea of the circular economy! The school is very proud of the Green Schools representativeswhoattendedtheconference!
InNovember2022-membersfromtheGreenSchoolscommittee metwithStephenO'ReillyfromNeatStreets,ananti-litterprogramme forsecondaryschools Theschoolisoneofonly31schoolsworking withNeatStreets ThankstoStephenforcomingtoEnniscorthy CommunityCollegetomeetwiththemandgivingthemlotsofideas topromoteclimateaction,sustainabilityandthegreenschoolsethos intheschoolandthecommunity
In November 2022, Transition Year students Keeva Fitzgerald, Stephen Boland and Andrea Doyle along with Principal Dr Iain Wickham received their certificate for their involvement in the Climate Literacy Project The event took place in the Ferrycarrig Hotel and was part of Wexford County Council EnvironmentAwards.



On Tuesday the 2nd May, four members of the Green Schools committee attended a "Neat Streets" award ceremony in the Gresham Hotel, Dublin Neat Streets is a programme developed by An Taisce to prevent litter and waste in schools and the local community The Green Schools committee has been working throughout theyeartacklingwasteandlitterthroughactivitieslikethe"GoGreenforSt Patrick"week,guestspeakersfrom Repak, clothes pod collection, litter picking and more On Tuesday, the four representatives gave a presentation outlining all the activities they have done this year and received an award for all their hard work. The Green Schools committee aim to continue in the next academic year and achieve our first green flag. Pictured are Hannah McInerney, Abbie Dobbs, Jack Redmond and Keanan Treacy, accompanied by Green SchoolsCoordinatorsMs AineSheeranandMs SarahWalsh Welldonetoall!

The Green Schools Committee organised a "Go Green for St Patrick!"- a week of activities and competitions basedonthetheme"LitterandWaste" StudentsmetwithClareDonellanfromRepakIrelandwheretheylearned allaboutrecyclingandwastemanagement


Students signed up to become environmental captains An environmental captain is a student who pledges to protect the environment and help tackle litter and waste in Enniscorthy Community College. They organised break andlunchtimegamesandactivities.

Theyran 3 competitions: a digital poster competition (to save paper), a Kahoot quiz on litter and waste, and a slogan competition Amy Williams (3 Holly) won the poster competition Andrew Pauce (1 Yew) won the Kahoot quiz Jude Dickson (1 Yew) won the slogan competition with their entry of "Leave nothing but footprints behind" Thesethreestudentseachwona€50EasonsvoucherandalargeEasterEgg
The3HollyclassmadetiktokstoentertheNeatStreetsIreland#instabin2023competition



Onthe2ndFebruary2023,TheGreenSchoolscommitteeattendedtheWetlands&coastalExhibitioninWexford County Hall to celebrate World Wetlands day The key focus of the group was: citizen science and sustainable action Students engaged with discussions, workshops and felt inspired to take action Parents and students alsoparticipatedintheecologicalphoto-exhibition aspartofWorldWetlandsDay

In November 2022, the Green schools team enjoyed getting their hands dirty, helping to enhance the biodiversityofthelocalcommunity Theywerebusypreparingthebedsforplanting





"Be Clean and Travel Green": Great to seeabicycleinoneofthebikeshelters. St Declan's Community College are encouraging students to cycle to school in the last term if it is safe to do so now thattheweatherisbetter

Well done to Green School members Jordan Mc Ritchie, Erika Larkin Power and Aoibhe McGrath, who have created a Green postboxforideaswiththehelpofMr WalshWoodworkteacher



Congratulations to St Declan's on receiving their 9th Green Flag Award from An Taisce in Kilkenny for Global Citizenship Travel. Well done to the 3rd year Green Schools Committee representatives Kate Galvin, Jordan Mc Ritchie and Erica Larkin PowerwithMsO'SheaCo-ordinator Nextyeartheywillstartwork onour10thFlaginBiodiversity!!

year Green Schools Committee students participating in an Bealtine Flower pressingeventintheLibraryinKilmacthomas

and


On the 17th May, the new green schools flag was lifted today with the deputy principal Ms. Furlong, Green School’s co-ordinator, Ms. Walsh and the committee. A massiveachievementfortheschool


In May 2023, the green school members took part intheGoreyClimateActioneventheldtodayinthe Gorey Council Chambers with climate coordinator Frank Burke. The students discussed the key themes, goals, aims and actions that may be included in the county’s Climate Action Plan alongside students from other Gorey secondary schools
Members of the Green School Committee at their monthly environmental meeting in the District Chambers They discussed further plans on bettering Goreytownanditspost-primaryschools


CongratulationstoMs WalshandtheGreenSchools Committee on receiving their new green school waterflagattheawardceremonyinKilkenny,inMay 2023

InMarch2022,LeavingCertstudentswentonaTriptoKildaltonAgriculturalCollege!


InDecember2022,3rdyearGraphicsstudentsexploredtherelationshipbetweenGraphicsand‘TheGeometry ofFoodPackaging’
In October 2020, the Transition Year students enjoyed a trip to SecretValleyFarminClonroche



BridgetownCollege
On the 8th March, 2023, Senior Cycle Agricultural Science students went to the Teagasc Farm at Johnstown Castle where they saw the milking facilities, the dairy herd and calves They finished their visit with a walk to the fields where they looked atthemultispeciessward


ColáisteAbbáin
16thMarch2023-1styearTechnicalGraphicstudents redesigned a car logo and added in a shamrock for their keyrings for St Patrick's Day Students used CAD andthelasertocutouttheirdesigns.

ColáisteanÁtha
On he 2nd December 2022 -Mr Murphy’s TY students in thesecondweekofusingOnShapefor3Dmodelingwhile they work through their 10 week sampling blocks for LC subjectchoices


On the 3rd May 2023, 3rd years had a great trip to Courtown last week where they paid a visit to the Seal Sanctuary as part of their CSPE studies While there they learned about animal conservation, animal welfare, pollution, the negative effects of human activity on wildlife and about the importance of volunteerism. During the visit the student got see first hand the work that goes into caringforyoungseals,injuredsealsandolderseals thatarejustaboutreadytoreturntothewild Itwas avery informativeandexcitingday

ColáisteAbbáin
Onthe10thMarch2023,2ndyearAgricultural Science class hosted students from Adamstown NS on a visited the Coláiste Abbain farm Students had great opportunities to earn about goats and poultry which coincides with their learning in Aistear




BunclodyCommunity College
TheTYstudentshadabusy morningsworkwithBunclody TidyTowns.Thestudents plantinguppotsforthe summerdisplayonthemain street Abigthankyoufrom theTidyTownstoMsFinnand theteachingstaffofthe schoolformakingithappen

BridgetownCollege
InOctober2022,firstyearstudentsgotcreativewhilelearningaboutcellsinScienceclass
On the 30th March 2023, Our 5th year Agricultural ScienceclassenjoyedAgriaware’s”FarmWalkand Talk” event in Kildalton Agricultural College last Friday The very informative and interesting visit explored carcase grading, sustainability, organic pest control, fertiliser application, dairy, meat marketing and much more Students were given a booklet of coursework material, including information to assist with development of their IIS reports. Well done to organisers of the event who managed to get 280 students and teachers through each stand within a restricted timeframe Lookingforwardtonextyear’seventalready!
ColáisteanÁtha
In December 2022, 2nd year Wood Technology students made serving tray made justintimeforChristmastea andcakes


3rd Class St Mary’s primary school enjoyed an amazing day in Dungarvan College, exploring all things STEAM (Science, Technology, Engineering, Art and Maths) They received a warm welcome and enjoyed delicious ice creams on departure They thoroughly enjoyed the experience The girls made friendship bracelets, tasted healthy smoothies, learned about nutrition, sampled coding, created beautiful felt art, participated in long jumps and timed sprints, got a taste for graphic design and played some fun Maths games.


Some of the 5th year students recently attended the student experience day on the UCD campus Students attended lectures in Architecture, Computer Science, Arts, Science and VeterinaryNursing Itwasafantasticexperience WelldoneCian,Charlotte,Daire,Eabha,Josh, LeahandLuizformakingthemostofthisstudentexperience

ColáisteAbbáin


InMarch2023-MrBarry'sScienceclassusedtheVandeGraaff generatortodemonstratehowelectricchargeaccumulates,andcauses chargedhairstrandstorepeleachother TheTYshadsomeforensicfun tryingtofigureoutwhoshotJFK Theylookedattimelinesofsuspects, gunsandbulletsused,motivefortheshootingandfingerprints.Students evengottolookattheirownfingerprints.

David Donnelly and Maurice Fehilly from Radley Engineering, Dungarvan visited the school to give a talk to 6 year Engineering students regarding apprenticeshipopportunities





ColáisteanÁtha
InDecember2022,LCA1Agricultural/Horticulturalstudentsweregettingtogripswithsomewinterplanting


EnniscothyCommunityCollege
On Tuesday February 7th was Safer Internet Day First and Second Years enjoyed a talk on Internet Safety andCyberbullyingbyGardafromtheCommunityPolicingUnitattachedtoEnniscorthyGardaStation

The Safer Internet Day Ambassadors - Linda Kavanagh and Shakira Waters (TY) lead the Internet Safety events for the week. They were assisted by Sam Doran, Lucy Williams, Molly Brady and Ben Murphy. They deliveredanInternetSafetyWorkshoptoallFirstandSecondclassesandranapostercompetition
ColáisteanÁtha
InNovember2022,LCAIandLCAIIAgricultural/Horticultural studentstravelledtoBeyondtheTreesat Avondale



Wheredidyoustudytobecomea teacherofyoursubject?
PastPupilof:
BridgetownCollege
No.ofyearsworking withWWETB:
30+years
Subjectsyouteach:
WoodTechnology,Construction Studies,Electronics&Coding, Safety&HealthtoPLCstudents
MartyBatesName:

Currentlyworkingin: DungarvanCollege
Whatdoyoulikemost aboutteachingina
WWETBschool:
The WWETB is well funded, well organised and takes the wellbeing ofemployeesseriously

ColáisteanÁtha
AgriculturalScienceTrip





Whatyoulovemostabout teachingyoursubject(s)?
Passingonskillsand knowledgetostudents enablingthemto expresstheircreativity usingavarietyof materials,tools, techniques,etc
Inspirationtobecomeateacher?
My mother was a primary school teacherinKilmoreNS,andmyfather, although he had no formal training, wasaverytalentedcraftsman
BunclodyCommunity College
ManythankstoMarie(Senior TrainingAdvisor/SOLAS) fromWWETBTraining Servicesforsettingupthe ApprenticeshipStandatBVC today Mariewasavailableto answerquestionsonthe multitudeofapprenticeships Studentsacrossallyear groupsinJuniorandSenior Cyclehadanopportunityto talktoMariefortheduration oflunchtime Itwasagreat opportunityforstudents
MathsWeek2022
ColáisteanÁtha

DuringMathsweek2022,Mr Ryan’s1B mathsstudentsworkingwiththeIzak9 games





Onthe18thJanuary 2023,ShakiraWaters andLindaKavanagh fromTY,thetwoSID Ambassadors,enjoyeda trainingdayatGoogle HeadquartersinDublin aspartoftheSafer InternetDay Ambassador Programme The Programmegives studentsanopportunity toleadanonlinesafety campaignintheirown school.Theybrought backlotsofgreatideas forourcampaigntaking placeon7thFebruary
Welldonegirls

DungarvanCollege
SETUdemonstratednewtechnologies. Majella Mc Carthy from the South East Technological University is currently working on a project with our First year students, to demonstratenewtechnologies


InOctober,2023, the3rdyearstudentsreceivedtheircertificatesinrecognitionofthework theycompletedinsendingamessagetotheInternationalSpaceStationearlierintheyear CertificateswerepresentedbyMr Ryanwhoworkedwiththestudentsonthisproject
ColáisteAbbáin


Great work by the 2nd year Agriculture/Horticulture students planting up their summer window boxes. Studentsplannedtheirdesignsandchosetheflowerswhichtheywantedtoplant.




6th Year Leaving Cert Applied group visited Kildaton Open Day and Training and the WWETB Training Centre Theylearnedaboutcoursesonofferandwere givenatourofthefacilities Theyalsogotgettoknow someofthenewarrivals!!


ColáisteAbbáin
HavealookatsomeoftheTYWoodworkprojects!
Onthe27thApril2023,theschoolhostedsomefantasticworkshopsforSTEAMDaywiththe3rd,4thand5th class students They participated in workshops for Science, Technology, Engineering, Art and Maths They absolutelylovedit!




Digital leaders entered the Cluster Competition for all the WWETB Schools recently and came 2nd place out of the 13 schools Well done to all the digital leaders who took part and helped produce this great film! Lots of hard work shown from this team oftheDigitalLeadersinTY
This video is about spreading awareness of whatyourdigitalfootprintis.
Many thanks to Nicholas Morris for filming, FeliciaCojanforeditingandahugethankyou toMissMurphyforhersupport

On the 16th January 2023, ECC HSCL and STAR (Supporting Traveller and Roma in Education) played host to a very successfulTravellerCelebrationlastThursdayintheschool Mr Andy Connors presented his Model Wagons and spoke of Travellerlifewhenhewasyoung.Hisgreatgrandsons,whoare currently students of ECC, showed visible pride and interest in learning about the wagons and way of life Mr Connors also urged the younger members of the Traveller Community to continuetolearnandpracticetheskillshandeddownbyolder generations and to blend these skills with the knowledge they learninschool ThelocalfilmHaltedwhichhaswonawardsat numerous Film festivals was then shown Students learned a lot about the Travelling Community, creating awareness of diversity and inclusivity. The event was organised by the STAR Project HSCL, Ms. Paula Doyle and ECC’s HSCL, Ms. Aileen Walsh Welldonetoallinvolved

‘Bin It’ roadshow performed for 1st and 2nd year students It was a great opportunity for thestudentstolearnaboutlitterandwaste!
Onthe12thOctober2022,BláthnaidNíChofaighandtheNationwideteam visitedthecommunitygarden Well donetoHSCLteacherJoeyRedmond,horticulturetutorJayFarran&ourTidyTownscommitteeonalltheirhard work



TY Scifest 20 took place on 10th May 2023 The students worked really hard completing their investigations over the a number of weeks and they all did a great job presenting them to the judges Congratulations to Viktoriia who came 2nd with her investigation on “Does height affect a volleyball spike?” and massive congratulations to Nikos,DahamandSeanÓg,whoseinvestigationon“Theeffectofdifferentcolouredlightsonplantgrowth”came in1stplace



ColáisteanÁtha
Onthe28thOctober2022,theTransitionYearAgriculturalSciencestudentsenjoyedafarmwalk




In November 2022, the 5LA students were very busy in the Woodwork department with their teacher Mr McMahon, creating and designing the new ukulele holders and hanging them in the music room The Music Department aredelightedwiththenewedition


1st and 2nd years participated in a great workshop presented by DR Barry Fitzgerald all about Superhero Sciencefor1stand2ndyearstudents

On 12th March 2023, Students at Coláiste Abbáin were presented with an exciting opportunity by the Co Wexford STAR project Students got the opportunity to participate in aWagonbuildingclass

In January 2023, Agricultural Science students got to see ultrasound scanning in action for the scanningofthesheep and the goats They are expecting three sets of twins with our goats and a set of twins and two single lambswiththesheep

International Day of Mathematics, Pi Day

Thisworldwidecelebrationofmathstakes place on March 14 (314 US date format)
Ms McMullen's third year maths students participatedinthePichallengehostedby DeLaSalleSecondarySchool


The school was delighted to welcome @mark thescienceguytothecollege Thestudentshad afunandengagingearningexperience
EnniscorthyCommunityCollege
On the 19th April 2023, First Year Wood Technology students completed their Toast Tongs Made from birch plywood and a beech wedge with a food-safe finish applied The students created fantasticdesignsketchesandcardboardprototypestoensureanergonomicdesign


ColáisteAbbáin
In April, 2023, Mr. Redmond's 1st year Scienceclassinvestigatedacids,bases andthepHvalueofdifferentliquids
CreaghCollegeoffered firstyearsachancetowinasciencescholarshipsponsoredbyMERCK The scholarship entails a trip to the award winning W5 science activity center in Belfast, participation in the marvellous machines workshop and an afternoon spent at the vertigo activity centre Lunch and transport wereincluded
1styearssciencescholarship students had a busy day in Belfast They started the day in the W5 where they explored four floors of Interactive science and technology exhibits and completed a workshop where they built some marvellous machines! Next they moved onto the inflatable adventure park in Vertigo


ColáisteanÁtha
InOctober2022,Mr O’Brien’sAgriculturalSciencestudentsrecreatedtheirfirstyearscienceclassphoto


ColáisteanÁtha
InSeptember2022,MsRochford’sLCAIIMathsclass ‘gottheirducksinarow’withcoordinategeometry
On the 11th January 2023, the Transition Year students visited BD Enniscorthy (formerly ClearStream Technologies) The students learned how BD design, develop and manufacture angioplasty devices for coronaryarterydisease,aswellasminimallyinvasivedevicesassociatedwithdiabetesandoncology. The students had an opportunity to insert a guidewire, balloon, and stent into a model, and look in on a Cleanroomwheretheseproductsaremanufactured



InApril2023-SecondyearAgriculture students enjoyed a walk to Rothwell’s farm where we got to see the pedigree flock of sheep and dairy herd. They stopped by a field of oilseed rape on the way back for a photoopportunity


ColáisteAbbáin

InMarch2023,AgriculturalScience studentsenjoyedadayattheAgriAwareFarmWalkwhichtookplacein Kildalton Agricultural College It was great opportunity for students to learn about sheep, beef, dairy, soil, horticultureandequine




ColáisteanÁtha
ParaicO'Keeffe Name:

Currentlyworkingin: CreaghCollege
Wheredidyoustudytobecomeateacher ofyoursubject?

UniversityofLimerick-B.Ed.inGraphics andConstructionTechnology
Whatyoulovemostaboutteachingyoursubject(s):
Ilovetheenthusiasmandthepositiveatmospherethatstudentsbring into the classroom. It is great to see students develop their skills, beliefs, attitudes and values from 1st year when some of them have never experienced the subjects before. It is rewarding to see them achieving remarkable things during their time in school and to see students develop their leadership skills through the values that WWETB put at the forefront of education. I am in a lucky position to have an opportunity to be part of students' journey in their transition through secondaryeducationandithasbeenaprivilegetosupportstudentsin aninclusiveenvironment.
PastPupilof:
BridgetownCollege
No.ofyearsworking withWWETB:
Subjectsyouteach:
T4(ConstructionStudies,DCG, GraphicsandWoodTechnology) 7years
Inspirationtobecomeateacher:
Contributingtostudentslivespositivelyinspiredmetobecomea teacher I have been lucky to have many role models in my life from an education perspective My parents have been a great support to me over the years My father taught in Bridgetown College for many years and shared the skills of woodwork with me when I was younger. My mother was there to guide me with homework and always put a strong value on education. My Graphics teacher Paddy Connick was an excellent role model in BridgetownCollegeandsharedhisloveofpracticalsubjectswith us as students. John Ormonde and Tadhg Foran, my former primary school teacher and Principal inspired me by putting a strongvalueofeducationandsportfromayoungage.Thereare many other teachers and mentors who have inspired me over the years and helped me gain the necessary confidence to achievesuccessineducation.
ColáisteAbbáin
Whatyoulikemostabout teachinginaWWETBschool:
I feel connected to the shared values and ethos that WWETB prioritises such as respect, care, excellence equality and the importance of community to maximise learners potential WWETB provide a high quality holistic education for children, young people and adults across a broad range of education and training programmes Extra-curricular activities are promoted and valued for our students to thrive outside the classroom Building strong relationships and having support among peers is a key area that I have found helpful in teaching and developingmyleadershipskills overthelastnumberofyears
2nd year students sowed over 300 sunflower seeds in aid of Naomi’sGnomesRelayforlifeteam Allfundsraisedwillgotothe Irishcancersociety

The Transition Year science class took part in “Scifest @ School” The students had been working on their science fair projects for weeks and finally got to compete against each other in the competition There were some really interesting and innovative ideas Congratulations to Caoimhe and Cassie who came in first place for their project – Does the sugar content influence a guinea pigs’ hay preference? Well done to all the students for their hard work in putting together these projects.


Also a ‘thank you ’ to Ms. Whelan, former science teacher DominicClancyandBillyFlemingfromScifestfortheirhelpwith judgingtheprojects
Well done to the TY Digital leaders (Josh Crowley, Daniel Power, Cian O'Rourke, Sara Norris, Daniel Tuc & Jack Coady) who recently produced a video on "My Digital Footprint" as part of the WWETB O365 Digital Cluster Competition They placed 3rd out of all the schools in WWETB Well donetoall!Thevideowas fantastic!

In September 2022 - The Transition Year theme of #community for this academic year was evident as the students did some great work, under the guidance of Mr Hearne, on the planned Tranquillity Garden A great starttotheyearandtotheproject





BunclodyVocationalCollege
Some 5th year students attended the UCD student experience day on the campus Students attended lecturesinArchitecture,ComputerScience,Arts,ScienceandVeterinaryNursing Itwasafantasticexperience (apartfromthe7amstart!) WelldoneCian,Charlotte,Daire,Eabha,Josh,LeahandLuizformakingthemost ofthisstudentexperience.

In January 2023, Junior classes and TY’s experienced Lismore Science Workshops They learned about creating circuits, the digestive system, the solar system and DNA Great enthusiasm and engagement in learning was veryevident





On the 11th May 2023, the Transition Years went on a trip to the National Botanic Gardens


First years were learning how to use the microscope in Science class They really enjoyed looking at some of the pre-prepared slides of algae, amoeba, blood smears andnervecells

Students from Selskar college attended the WorldSkills Ireland 2022 in the RDS - an event celebrating apprenticeships,tradesandskills-preparingthetalentoftodayforthecareersoftomorrow





The science room is a hive of activity every Monday as the weekly STEM club meets to investigate all things Science,Technology,EngineeringandMaths

Second years were flying into midterm! Fantastic work completed by second year students in Mr Martin's Engineeringclasses Sometopclasswork


Congratulations to the Transition Year students that were selected as the Digital Leaderfor2022/2023


ColáisteAbbáin
InNovember2022,aspartofaTY'steambuildingexercise,studenthadtoscaleuptheoriginalprintedsketch of their chosen car and work out the proportions as a team along with developing sketching and shading techniquesintheprocess


Creagh College
Well done to the Digital Leaders, who went through an interview process to become a Digital Leader in Creagh College This initiative supports the school's approach to mentoring young leaders and to further develop the ICT skills of our pupils and adults This innovative approach to education, utilising the latest digital technologies is further supported by the DigitalLeaders.

BunclodyVocationalCollege
Congratulations to Ms Doyle and her students who qualified once again for the Regional Final of the Junk Kouture competition

MarinaIniguezRimadaispicturedwithher creation "Synthetic Polar" Kate McGlynn Greeneisalsopicturedmodellinganoutfit entitled "Fiercely Feminine". This unique design was created by Stacey Power, Ellie WatchornandKateherself
We wish all the students involved, and Ms Doyle the very best in the next round of thecompetition


St.Paul'sCommunityCollege
Four first years came second in the National finals of the EU Conexus schools competition about green and sustainable schools. Their project was on solar panels and recycling in the school The students involved were: Leigha Kinsella, Alex Simpson, Josh O’Donoghue and Daniel O’Sullivan Westpal They also took part in the SciFest in SETU with their project called Solar Panels -A Brighter Future for four School using MicrogenerationTechnology
BunclodyVocationalCollege
TY students, Kate, Kellie and Rachel completed the Maynooth University Science Laboratory

Placement This hands-on laboratory-based week covered areas such as Evolution, Immunology, Environmental Science They carried out techniques in Microbiology, Biochemistry & Molecular Genetics The students alsogotachancetoseetheResearchLabsand ScientistsinAction.Itwasafantasticexperience for the students as accommodation was provided,sotheygotatasteofcollegelifewhile learning many laboratory techniques and skills The school have secured three places in next yearinthisprestigiousprogramme
In January 2022, Billy Fleming from @scifest introduced SciFest to the TY students ItwasgreattoseeSciFestin action again this year in Bridgetown College

BridgetownCollege
TheTYstudentshavetakingpartinthe@agriawareFoaltoRaceprogram Theyhadaveryinformativevisit to the Irish National Stud Students got to see the stallions, mares and foals and had a Racehorse Experience

TY students learned about about familiar with some ‘building materials’ from the Construction Studies taster Concrete blocks of different sizes, DPC, wall ties, etc All items were sketched, measured, and all measurementsaddedtothesketches


Ms Forristal's 6th year Biology students carried out anexperimenttoprepareandshowtheproduction of alcohol by yeast in class The students also performedtheseexperimentsattheOpenDay



St Paul'shavebeenverybusyplanting5nativeIrish trees within the grounds of the College The students had prepared the ground for "Waterford Trees for Life" and helped to plant, stake and water thetrees

Thank you so much to the first year students and their teachers who researched the importance of plantingnativetreesandplantstoattractbeesand insects in their Environmental Studies and CSPE classes
A special thanks also to the Waterford Shopping Centre, Lisduggan who sponsored the trees and to the "Waterford Trees for Life" volunteers from the Lions Club who sourced and provided their expertise
TYwoodworkclasswerebusycraftingtheirbirdfeeder Studentsworkedwithplywood,MDFandpine,studentsare buildingontheirknowledgeofvariousmaterials Basic jointingtechniqueswereusedonthisproject-buttjoints, glueandscrews Panelpinswerenailedintothebaseand theroof

Name:

Anne-MarieToomey
School: BridgetownCollege
Wheredidyoustudytobecomeateacherof yoursubject?
UniversityofLimerick-B.TechMetal& EngineeringTechnologyandM TechComputer IntegratedManufacturing
Subjectsyouteach:
Engineering CurrentlyworkingasDigital LearningSupportinWWETB
Inspirationtobecomeateacher:
PastPupilof:
ColáisteAbbáin
No.ofyearsworking withWWETB:
My teachers in Coláiste Abbáin were great role models and inspired me to become a teacher especially Mr Haddigan my Engineering teacher Mr Haddigan was hugely supportive to me during my time in school and college My mother did primary school subbing and my dad has an engineering business so becoming an Engineeringteacheragoodmixofboth 17years
Whatyoulovemost aboutteachingyour subject(s)?
Iloveteachingthe practicalskillsof engineeringteachingstudentslife skills Ihopethatbeing afemaleEngineering teacheritmight inspiregirlstogointo theworldof engineering.
WhatyoulikemostaboutteachinginaWWETB school:
WWETB gives students the opportunity to study a widevarietyofsubjects Ibelievethatworkingwithin the WWETB gives us a strong sense of community and support It gives staff the opportunity to grow and develop through communities of practice WWETB offers an inclusive education in a caring environment, allowing students to flourish and grow and maybe inspire them to be future educators In my current role, I get to work with people from all acrosstheorganisation
WomeninTech-SETU St.Paul'sCommunityCollege
SeniorstudentscelebratedWomeninTech DayintheSETUwherevariouscareersand apprenticeships were explained and highlightedtoourstudents

ColáisteAbbáin
1st year Irish were busy using the whiteboards to complete their spelling test in pairs and then engaging in Numeracy in Assessment, calculating theirowngradesattheendofclasson theirProgressReports

ColáisteanÁtha
Mikolaj Perek 1st year ws the overall winner of the Wexford County Council Wildflower poster competition judged by famous Artist Don Conroy Ms Reddy would like to congratulate Mikolaj on all his hard work creating a beautifulposter!



Deise Animal Sanctuary visited the TY and 1st year students. Rob along with his furry colleagues gave an educational talk on animal welfare in the JCSP library He spoke about the sanctuaryandresponsiblepetcare



In September 2022, the 1st year Agriculture students visited Rothwell's farm as part of their subject taster programme Studentsgotagreatinsightintohowafarmoperates




St.Paul'sCommunityCollege
BunclodyVocationalCollege
TYstudentswerebusy atwork duringMr
McMahon’sWoodcrafts classontheirvarious projects.Onegroup wasputtingthe finishingtouchesto flowerboxeswhichthe TYhorticultureclasswill fillwithspringflowers


JCSP Mathematics trip to Beyond The Treetops in Avondale,whereamixture of 2nd and 3rd year students took part in A Maths Eye nature walk and braved the largest slideinIreland
Some of the brave adventurers could be heard screaming back in Waterford during the fast descent!
JunkKouture
CreaghCollege
Creagh College had a Junk Kouture Dublin City Finalistin2023!!

Una Fae Flavin successfully made it out of the Regionals and into the live show in May with her entry'Glamping'!
A group of Senior Cycle students attended the ‘World Skills Expo Ireland’ in the RDS, which showcases all the apprenticeshipsavailabletostudents Therewas‘handson ’ practical demonstrations, as well as lots of stands andinformation AbigthankstoMr CollinsandMr Walsh fororganisingthetrip



St.Paul'sCommunity College
1st year Science students returned to school after midterm with their space projects Well done everyone what a great effort from all students



Members of 2A and 2S took part in the TIMMS (Trends in International Mathematics and Science) study TIMMS assessestheMathsandScienceskillsof4thclassand2nd year students internationally every three years Well done toeveryonewhotookpart!"

Enniscorthy CommunityCollege
There are lots of amazing Science books to borrow in the JCSP library for the students in Enniscorthy Community College The JCSP library is always a hive of activity and very activeatlunchtimes


Fiona Dee and Anne-Marie Toomey from Digital Learning visited BETT 2023 in the ExCel Exhibition Centre in London from March 29th-30th BETT, the biggest Education Technology exhibition in the world (over 30,00 attendees) showcases the most recent developments in educational technology Some of the main themes this year were Esports, Virtual Reality, Acessibility tools andAIineducation
There was a packed house for Dan Fitzpatrick’s talk on The AI Classroom: Teaching and Learning in the ChatGPT era Dan is a renowned AI Educator who empowers teachers to gain value fromAI HeprovidedgreatinsightsusingAIasateachingtool Augmentedrealityandvirtualrealitywereprominentateveryturn intheBETTArena
Esports is finding its way into educational systems Esports courses can be leveraged to inspire students to become lifelong learners and develop the critical skills necessary to unlock excitingfutureswiththepowerofgame-basedlearning Overall,experiencingandwitnessingfirst-handthedevelopments in digital tools across education reenergised Digital Learning's discussionandplanningfortheacademicyearahead.
EnniscorthyCommunityCollege
On 8th May, 2023 Mr Filip Vurm, Deputy Head of Mission at the Czech Mission in Dublin visit the schoolforEuropeDay Hewasaccompaniedby Minister of State at the Department of Justice, JamesBrowneTD

Mr Vurm held a lively Q&A discussion with First Year Students on the work of the Union and its response to Climate Change Mr Vurm the visited the Boro suite and met and talked with staffandstudents.Inthephotofromlefttoright, James Browne TD, Mr. Filip Vurm, Deputy PrincipalTinaMerrimanandConorDempsey.

St.Paul'sCommunityCollege
3rd year students had a fantastic day on their environmental studies day - Botany & Bird life in Fenor Bog They attended a Farm to food talk by Mr Lawrence Curran of Copper Coast Mini Farm as well as bottle feeding the lambsandotheranimals,Tofinishthedaystudentswalked the Anne Valley where they learned how the Reed beds are filtering the stream so that the water running into Annestown beach is clean They observed many plant and bird species Thanks to their teachers for a great day Ms Hennessy,Ms Downes,Ms Carthy,Ms Brennan,Mr ODwyer andMr McGrath



St.Declan'sCommunityCollege
Congratulations to 3rd year Graphics students: Aoife Laffan, Erica Larkin Power, Lauren McAleer, Ben Latham, Liam Reade, Ben Conway along with classteacherMrCollinsreceivingtheirCertificatesofContributionforhaving their work displayed by the Royal Institute of Architects Ireland online exhibition2023 MissingfromthephotoisKateGalvin

InternationalWomen'sDay

St.Paul'sCommunityCollege
FirstandsecondyearstookpartinSTEM workshopsonInternationalWomen'sDay!





